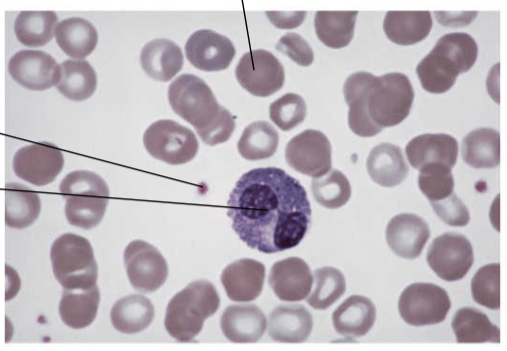
term image
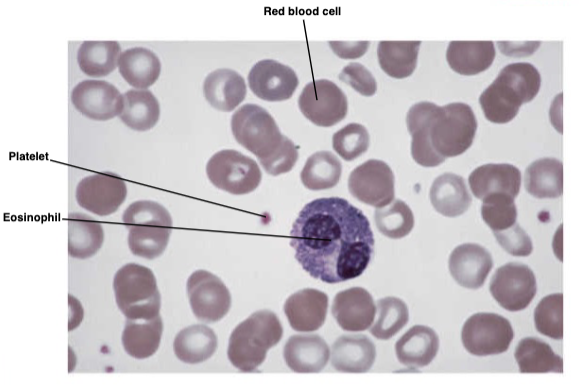
knowt flashcard image
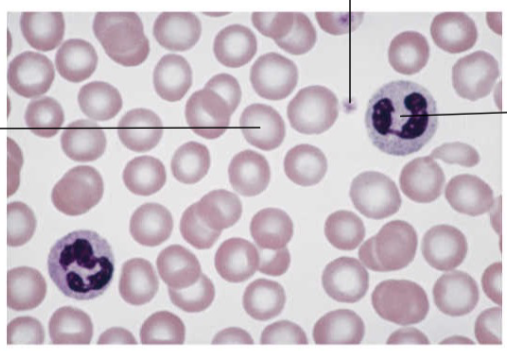
term image
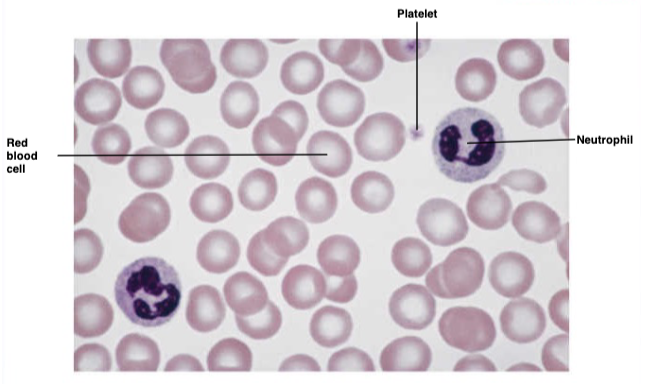
knowt flashcard image
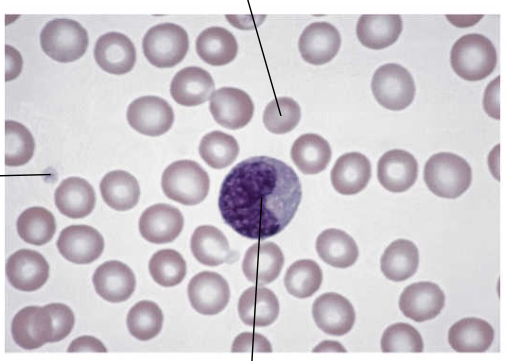
term image
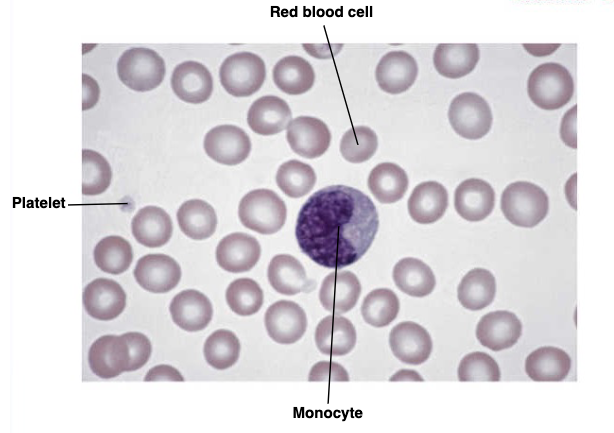
knowt flashcard image
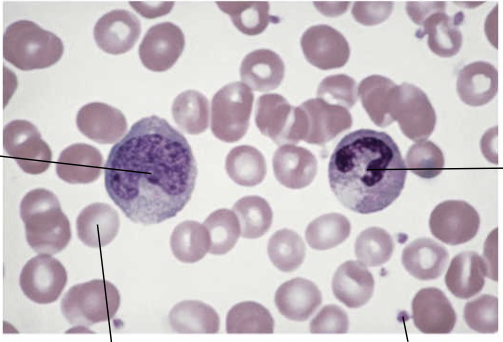
term image
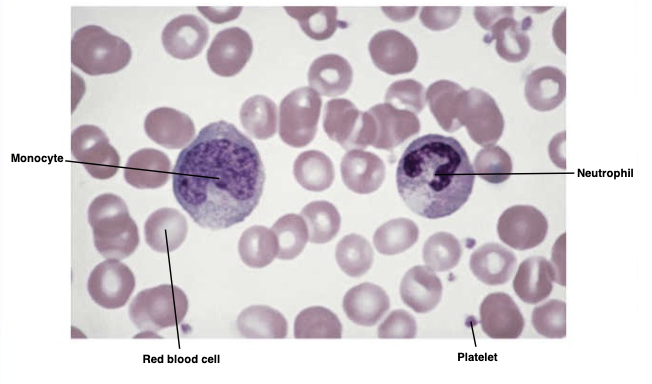
knowt flashcard image
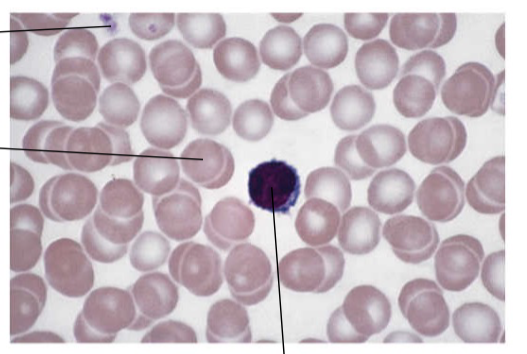
term image
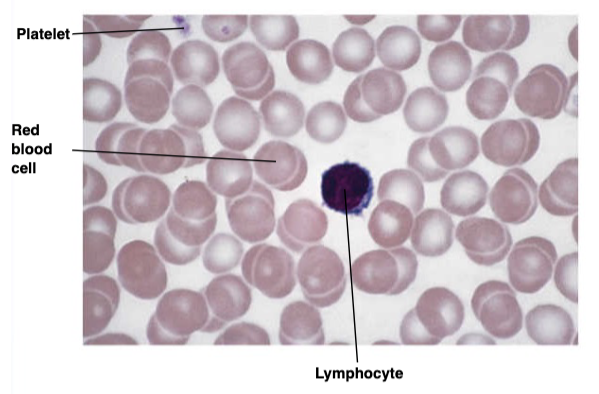
knowt flashcard image
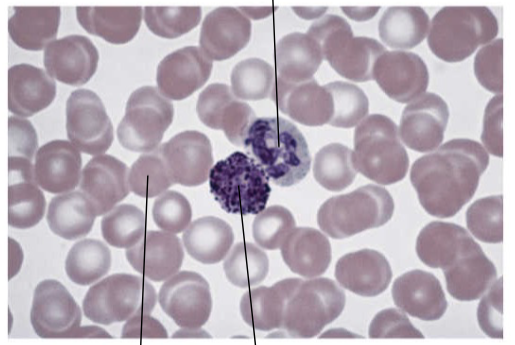
term image
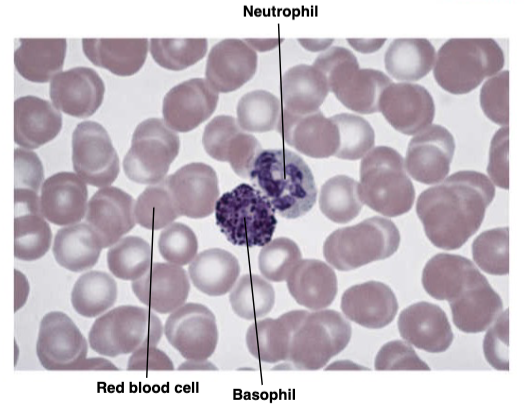
knowt flashcard image

1/126
Looks like no tags are added yet.
Name | Mastery | Learn | Test | Matching | Spaced | Call with Kai |
|---|
No analytics yet
Send a link to your students to track their progress

What are vasa vasorum
Vessels of Vessels
Are cardiac muscle branched
Yes
What do intercalated disks consist of
Gap junctions and desmosomes
How many nuclei and mitoch. in a heart cell
1 nuclei and many mitochondria
Heart electrical conduction order
SA node, AV node, bundle of his, bundle branches, purkinje fibers
What are desmosomes job
responsible for maintaining integrity of tissues, prevent ripping during relaxation
What are heart cells called
Myocytes
What are vena comitantes
Paired veins that accompany an artery, typically in the limbs. They lie on either side of the artery and run together within the same connective tissue sheath. Their close relationship helps facilitate venous return by using the pulsations of the artery to assist blood flow. Commonly found with smaller arteries, especially in the forearms and legs.
What are the 3 types of capillaries
Continuous = tight
Fenestrated = “windows”
Sinusoidal = large open spaces
Whats the space inside a vein or artery
Lumen
3 wall layers of arteries or veins
tunica intima, media, and externa
muscle layer between intima and media
internal elastic lamina
muscle layer between media and externa
external elastic lamina
What direction do veins point
Toward the heart
Moderator band
Septomarginal trabecula
Muscular band in the right ventricle
Runs from interventricular septum → anterior papillary muscle
Carries part of the right bundle branch (conduction system)
Helps coordinate ventricular contraction
Fossa ovalis
Depression in the interatrial septum (right atrium)
Remnant of the foramen ovale (fetal circulation)
Function in fetus: allows blood to flow right atrium → left atrium (bypasses lungs)
Closes after birth when pressure in the left atrium increases
Pectinate muscles
Comb-like muscular ridges in the atria
Prominent in the right atrium and auricles (atrial appendages)
Help increase force of contraction without greatly increasing mass
Located anterior to the crista terminalis in the right atrium
Anastomosis
a connection between two blood vessels, Can be between arteries, veins, or both, Provides alternate pathways for blood flow (collateral circulation)
Superarenal vein
Drains blood from the adrenal (suprarenal) glands
Right suprarenal vein → inferior vena cava
Left suprarenal vein → left renal vein
Important asymmetry between right and left sides
Is there a great saphenous artery?
no
What vessels supply the myocardium?
Coronary arteries
Arise from the Ascending aorta (just above the aortic valve)
Two main arteries:
Right coronary artery
Left coronary artery
Supply oxygenated blood to the myocardium (heart muscle)
Which vessels join to form the IVC
Formed by the union of the Right common iliac vein and Left common iliac vein
Peyer's patches
intestinal lymph node
What does blind end mean referring to the lymphatic system
Cut off, closed, single direction
What does the lymphatic system do?
Returns excess tissue fluid to the bloodstream (fluid balance)
Absorbs dietary fats from the intestines
Provides immune defense against pathogens
Includes vessels, lymph, and organs like the Lymph nodes, Spleen, and Thymus
Is hydrostatic pressure flow in or out
Out
Is oncotic pressure flow in or out
In
What is the flow of lymph
capillary, vessel, trunks, ducts